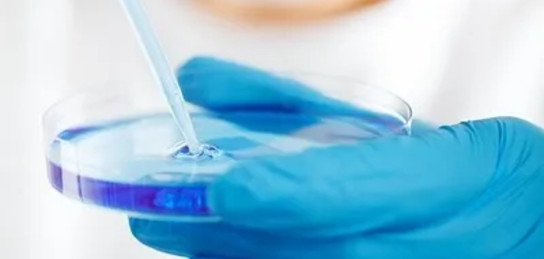

Для лечения ожогов в Швеции разработали «кожу в шприце»
© Фото: pixabay
Специалисты Университета Линчепинга разработали инновационный гель с живыми клетками – "кожу в шприце", которую можно использовать для пересадки при лечении ожогов, сообщает Zakon.kz.
Как пишет издание Advanced Healthcare Materials, при ожогах часто пересаживают только верхний слой кожи – эпидермис. Однако такая пересадка приводит к образованию грубых рубцов, так как отсутствует более глубокий и сложный слой – дерма. Именно дерма содержит кровеносные сосуды, нервы и волосяные фолликулы, которые отвечают за эластичность и полноценное функционирование кожи.
Отмечается, что создать дерму в лаборатории сложно, так как она состоит из множества разных структур. Специалисты решили найти другой подход: пересадить "строительные блоки" – клетки соединительной ткани (фибробласты), которые легко выращиваются в лаборатории и могут превращаться в разные типы клеток в зависимости от нужд организма.
Согласно данным портала, для этого клетки выращивали на крошечных желатиновых шариках, похожих по составу на коллаген кожи. Чтобы гель с такими шариками удерживался на месте раны, ученые смешали его с гиалуроновой кислотой и соединили компоненты с помощью химической реакции, образовав прочный и удобный для нанесения материал – "кожу в шприце".
Также портал пишет, что в эксперименте небольшие пластинки из такого геля напечатали на 3D-принтере и имплантировали под кожу мышей. Клетки успешно выжили, начали вырабатывать вещества для создания новой дермы, а в трансплантатах образовались кровеносные сосуды – важный шаг для выживания тканей в организме.
Ученые уверены, что новый материал может стать эффективным средством для восстановления полноценной кожи у пациентов с ожогами. Но для подтверждения эффективности новой методики нужны дополнительные исследования.
Ранее сообщалось, что японские ученые создали роботизированное лицо с живой кожей.
Источник: zakon.kz
Подписывайтесь на наш Telegram-канал. Будьте в курсе всех событий!
Мы работаем для Вас!
Читайте также:
-
06:16, 15 декабря 2025
Пуск ракеты «Протон» с космодрома Байконур срывается по техническим причинам
-
05:00, 15 декабря 2025
Умер композитор Левон Оганезов
-
01:51, 15 декабря 2025
Кровавая бойня в Сиднее: число погибших возросло до 16 человек
-
21:37, 14 декабря 2025
«Шар смерти» нашли у берегов Антарктиды
-
19:40, 14 декабря 2025
Космонавт снял завораживающие кадры величественных гор Памира с борта МКС





















